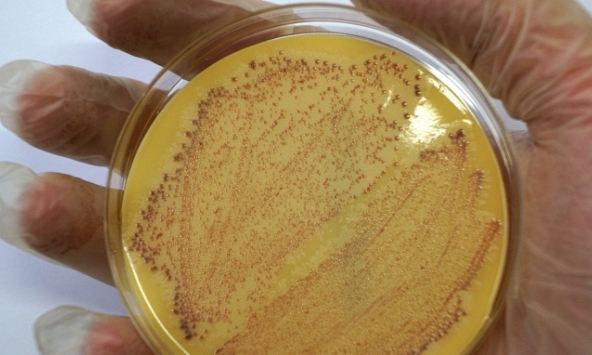
Cô gái 29 tuổi vốn khỏe mạnh tử vong 10 ngày sau khi nhiễm siêu vi khuẩn 'đục lỗ phổi'

Hầu hết mọi người cho rằng chỉ cần rửa sạch lòng nồi cơm điện hoặc lau qua bên ngoài là đủ. Tuy nhiên, trên thực tế thì cấu tạo của nồi cơm điện rất phức tạp và có nhiều chỗ bụi bẩn, hơi nước, vi khuẩn, côn trùng có thể ẩn náu. Nếu lâu ngày không vệ sinh có thể ảnh hưởng tới chất lượng cơm, sản sinh nấm mốc gây bệnh tật và thậm chí là ung thư, tăng nguy cơ cháy nổ khi sử dụng.
Vì vậy, ngoài lòng nồi bên trong, còn có 4 vị trí trên nồi cơm điện chúng ta cần kiểm tra mỗi ngày và làm sạch thường xuyên:
1. Lỗ thông hơi
Trong quá trình nấu cơm, hơi nước sẽ thoát ra qua các lỗ thông hơi của nồi cơm điện. Nếu phần nước này không được làm sạch kịp thời sẽ sản sinh ra vi khuẩn Salmonella, Escherichia coli, Staphylococcus aureus. Thậm chí lâu ngày còn có thể sản sinh ra nấm mốc chứa chất gây ung thư cấp độ 1 là Aspergillus aflatoxin. Những vi khuẩn, chất độc này sẽ chảy ngược vào nồi cơm điện vào lần sử dụng tiếp theo, làm ô nhiễm thực phẩm và gây nguy hiểm cho sức khỏe của bạn.
![]() |
Bên cạnh đó, nhiều người còn sử dụng nồi cơm điện để hầm thịt, nấu các món dầu mỡ khác. Vì vậy, nguy cơ nhiễm khuẩn, bít tắc lỗ thông hơi cũng cao hơn. Ngoài gây hại cho sức khỏe khi ăn cơm chứa chúng, còn tiềm ẩn nguy cơ cháy nổ trong khi sử dụng rất nguy hiểm. Nhất là với các loại nồi áp suất cao.
Khuyến nghị làm sạch: Hiện nay, nhiều thương hiệu nồi cơm điện được thiết kế nắp lỗ thoát hơi có thể tháo rời để dễ dàng vệ sinh. Với cấu trúc có thể tháo rời này, tất cả các bộ phận có thể tháo rời (như nắp lỗ, vòng cao su lỗ thoát hơi) trong quá trình vệ sinh, rửa sạch và lau khô. Cần lưu ý rằng tạp các chi tiết gần lỗ thông hơi thường có cấu trúc tinh tế và kết cấu mềm mại, vì vậy hãy cẩn thận để không làm hỏng chúng khi tháo rời.
2. Vòng cao su xung quanh nắp nồi
Vòng đệm cao su ở xung nắp nồi cơm điện có tác dụng kết nối, giữ chặt phần nắp nồi với thân nồi, đảm bảo đóng kín nồi cơm điện. Trong quá trình nấu nướng, hơi nước cùng các thực phẩm trong nồi khó tránh khỏi tiếp xúc với vòng cao su ở và sản sinh ra một lượng lớn vi khuẩn và nấm mốc.
![]() |
Chúng ta có thể phát hiện nấm mốc hoặc một lớp chất nhầy màu nâu, vàng, đen ẩn bên trong sau khi mở vòng đệm cao su này của nồi cơm điện. Lần sau bạn mở nắp, nước cất chảy xuống vòng cao su sẽ chảy vào nồi và làm bẩn thực phẩm nấu trong nồi, gây hại cho sức khỏe.
Khuyến nghị làm sạch: Hiện nay, hầu hết các thương hiệu nồi cơm điện đều có vòng cao su bịt kín ở nắp trên có thể tháo rời. Bạn chỉ cần tháo ra, mở hai bên vòng cao su và rửa sạch. Nếu là loại không thể tháo được thì dùng tăm bông nhúng baking soda và giấm trắng lau lại để loại bỏ các vết bẩn cứng đầu.
3. Hộp chống tràn
Hầu hết các nồi cơm điện còn được trang bị hộp đựng nước để chống tràn. Tuy nhiên vị trí rất khuất, lấy ra không dễ dàng, kích thước nhỏ khiến nhiều người bỏ quên hoặc cố tình bỏ qua khi vệ sinh nồi cơm điện. Nhưng nếu không đổ nước thường xuyên, không rửa hoặc rửa không sạch sẽ gây mùi hôi, phát sinh nấm mốc… gây hại. Đôi khi, các loại côn trùng như gián sẽ chui vào cấu trúc dọc theo hộp đựng nước. Hoặc nước quá đầy, tràn ra làm tăng nguy cơ cháy nổ khi nấu.
![]() |
Khuyến nghị làm sạch: Đừng bao giờ đợi cho đến khi hộp chống tràn đầy rồi mới đổ đi. Tốt nhất là nên đổ hàng ngày hoặc tối đa 1 tuần 1 lần. Tháo hộp chống tràn ra ngoài, cọt rửa kỹ, chờ khô ráo rồi lắp lại cho khớp mới sử dụng.
4. Mâm nhiệt bên trong nồi
Cũng có nhiều người thường lau bên ngoài nồi cơm điện, bao gồm cả đáy phía dưới ở bên ngoài của nồi. Nhưng đáy bên trong - tức mâm nhiệt của nồi cơm điện thì lại ít được quan tâm. Trong khi đó, cặn thức ăn, nước nhỏ giọt và cơm vô tình rơi xuống đáy nồi sẽ khiến mâm điện chuyển sang màu vàng, đen, bám cặn theo thời gian. Điều này không chỉ mất mỹ quan, mất vệ sinh, ảnh hưởng tới mùi vị của thức ăn mà còn làm giảm hiệu suất hoạt động của nồi. Lâu ngày còn có thể gây chập điện và cháy nổ nguy hiểm.
![]() |
Khuyến nghị làm sạch: Dùng bàn chải nhỏ nhúng vào baking soda hoặc chất tẩy rửa chuyên dụng để chải dọc theo đường của mâm tản nhiệt. Sau khi vệ sinh, lau sạch bằng vải mềm khô vừa phải và chờ khô hẳn mới dùng. Cũng nên lật ngược nồi để những cặn bẩn nằm sâu trong đáy nồi rơi ra. Cần lưu ý khi vệ sinh đáy nồi phải tắt nguồn và không được ngâm vào nước, nếu không có thể gây đoản mạch, thậm chí có thể gây điện giật.
Nguồn và ảnh: Aboluowang, Healthline

Người đàn ông nhiễm "vi khuẩn chết người" từ điều hòa, đừng xem nhẹ những tác nhân tàn phá cả gan, thận và phổi
6 thói quen khi giặt sấy khiến quần áo càng giặt càng bốc mùi, vi khuẩn sinh sôi nhanh chóng
4 mẹo ít người biết khi ăn trái cây giúp nhận tối đa dinh dưỡng, tránh vi khuẩn tấn công
Đũa dùng sai cách sẽ thành "ổ vi khuẩn" huỷ hoại sức khoẻ, từ loét dạ dày, bệnh gan đến ung thư đều có thể "gõ cửa"
Bé trai 2 tuổi nhiễm vi khuẩn ăn thịt người, phải cắt cụt chi vì nghịch cá ở chợ
Cô gái 29 tuổi vốn khỏe mạnh tử vong 10 ngày sau khi nhiễm siêu vi khuẩn "đục lỗ phổi"
Cùng chuyên mục
Mỹ nhân Việt mắc bệnh hiếm chỉ 2% dân số thế giới gặp phải
Thiếu nữ 16 tuổi qua đời vì suy thận, người mẹ tiết lộ bí mật liên quan đến điều gần như cô gái nào cũng "ám ảnh"
Người phụ nữ 50 tuổi bị tê chân nhưng lại phát hiện ung thư đại trực tràng giai đoạn cuối, không thể phẫu thuật
Sau tuổi 45, việc kiểm tra sức khỏe này là bắt buộc: Ngoài tác dụng sàng lọc ung thư còn phát hiện các bệnh dễ dẫn đến ung thư!
Xuất huyết đầu thai kỳ kiểu này nguy hiểm nhất, các mẹ bầu nhất định phải đi khám ngay
Người phụ nữ 32 tuổi sống lành mạnh nhưng mắc ung thư gan, bác sĩ thở dài: "Rau này ăn ít thì tốt, ăn nhiều thành độc"